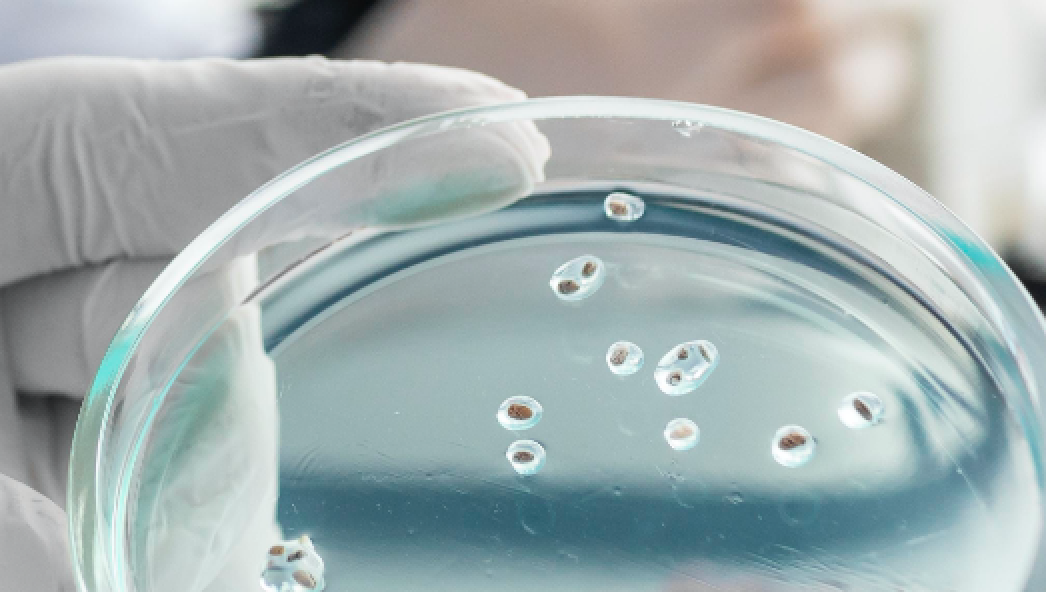
Agar
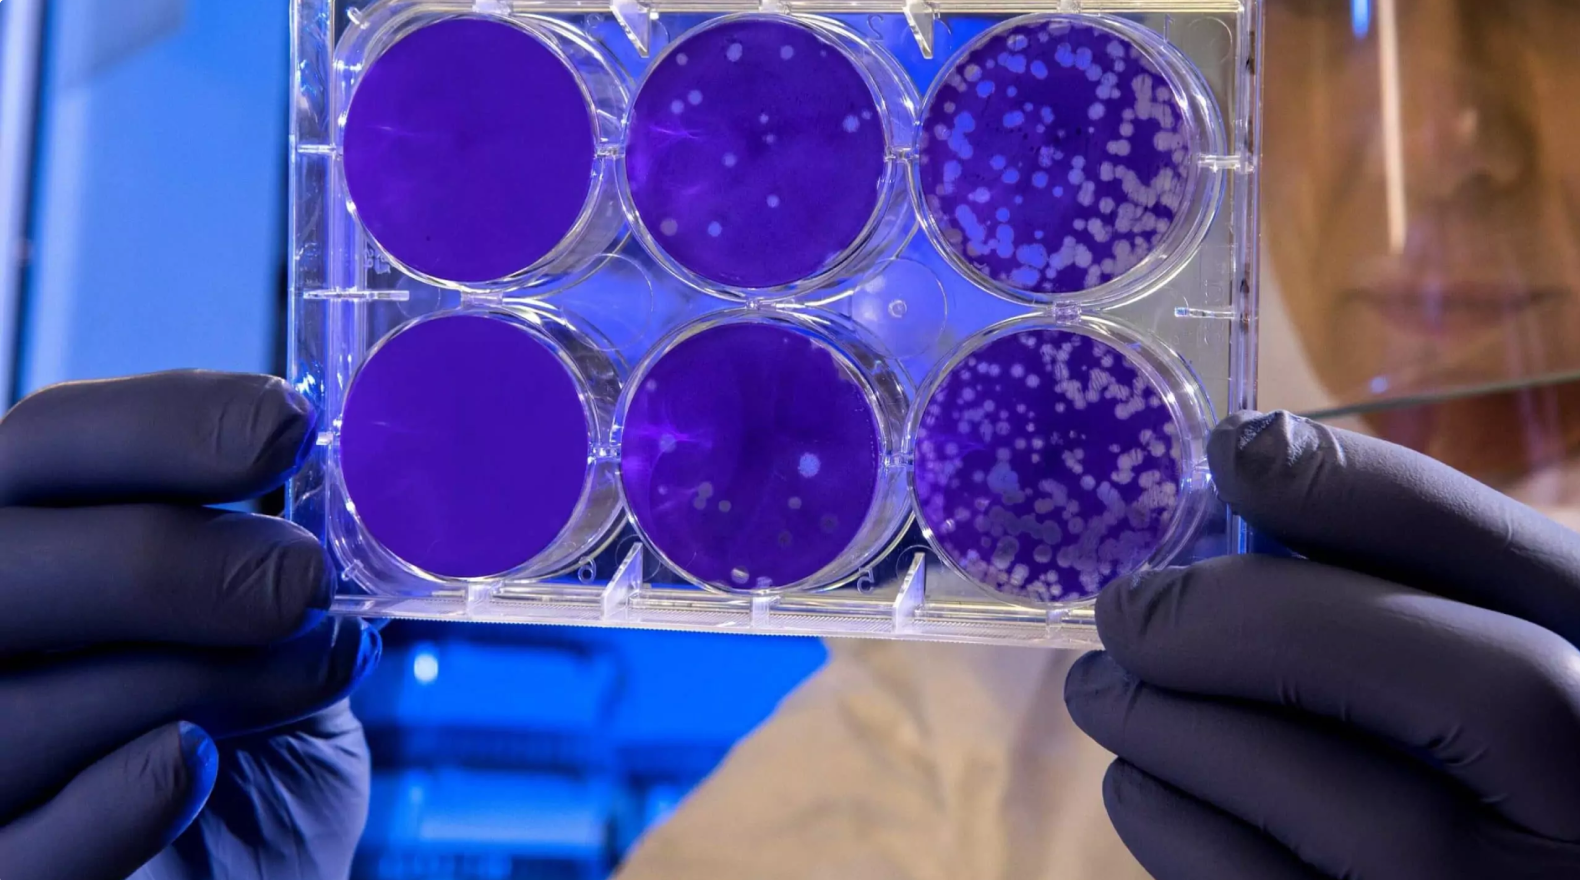
Ai in pharma drug discovery

Keep all learning & development processes in one place. Automate onboarding, knowledge sharing, and skill assessment. Invest in people, build a forward-thinking organization.

An AR platform for remote collaboration with experts, interactive work instructions, and hands-on training – that you will create with ease.

An AR platform for remote collaboration with experts, interactive work instructions, and hands-on training – that you will create with ease.

Microbial colony detection SDK and a dataset for accurate deep learning bacteria detection